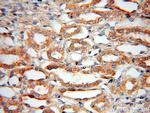
Bif-1 Antibody in Immunohistochemistry (Paraffin) (IHC (P))

Search
Proteintech
Bif-1 Polyclonal Antibody
{{$productOrderCtrl.translations['antibody.pdp.commerceCard.promotion.promotions']}}
{{$productOrderCtrl.translations['antibody.pdp.commerceCard.promotion.viewpromo']}}
{{$productOrderCtrl.translations['antibody.pdp.commerceCard.promotion.promocode']}}: {{promo.promoCode}} {{promo.promoTitle}} {{promo.promoDescription}}. {{$productOrderCtrl.translations['antibody.pdp.commerceCard.promotion.learnmore']}}
产品信息
15422-1-AP
种属反应
宿主/亚型
分类
类型
抗原
偶联物
形式
浓度
规格
纯化类型
保存液
内含物
保存条件
运输条件
产品详细信息
Immunogen sequence: MNIMDFNVK KLAADAGTFL SRAVQFTEEK LGQAEKTELD AHLENLLSKA ECTKIWTEKI MKQTEVLLQP NPNARIEEFV YEKLDRKAPS RINNPELLGQ YMIDAGTEFG PGTAYGNALI KCGETQKRIG TADRELIQTS ALNFLTPLRN FIEGDYKTIA KERKLLQNKR LDLDAAKTRL KKAKAAETRN SSEQELRITQ SEFDRQAEIT RLLLEGISST HAHHLRCLND FVEAQMTYYA QCYQYMLDLQ KQLGSFPSNY LSNNNQTSVT PVPSVLPNAI GSSAMASTSG LVITSPSNLS DLKECSGSRK ARVLYDYDAA NSTELSLLAD EVITVFSVVG MDSDWLMGER GNQKGKVPIT YLELLN (1-365 aa encoded by B C007455)
靶标信息
Bif1 gene encodes a protein similar to a protein in rodents which is induced by bone morphogenic protein 2 in vitro and may be involved in BMP2-induced transcription.
仅用于科研。不用于诊断过程。未经明确授权不得转售。
生物信息学
蛋白别名: Bax-binding protein; Bax-interacting factor 1; Bif-1; BIF1; endophilin b1; Endophilin-B1; KIAA0491; protein phosphatase 1, regulatory subunit 70; SH3 domain-containing GRB2-like protein B1; SH3-containing protein SH3GLB1; SH3-domain GRB2 like endophilin B1; SH3-domain GRB2-like B1 (endophilin); sh3glb1 {ECO:0000312|EMBL:AAH79085.1}; testicular tissue protein Li 172; unnamed protein product
基因别名: AA409932; AI314629; AU015566; Bif-1; CGI-61; dJ612B15.2; KIAA0491; mKIAA0491; PPP1R70; SH3GLB1
UniProt ID: (Human) Q9Y371, (Rat) Q6AYE2, (Mouse) Q9JK48
Entrez Gene ID: (Human) 51100, (Rat) 292156, (Mouse) 54673